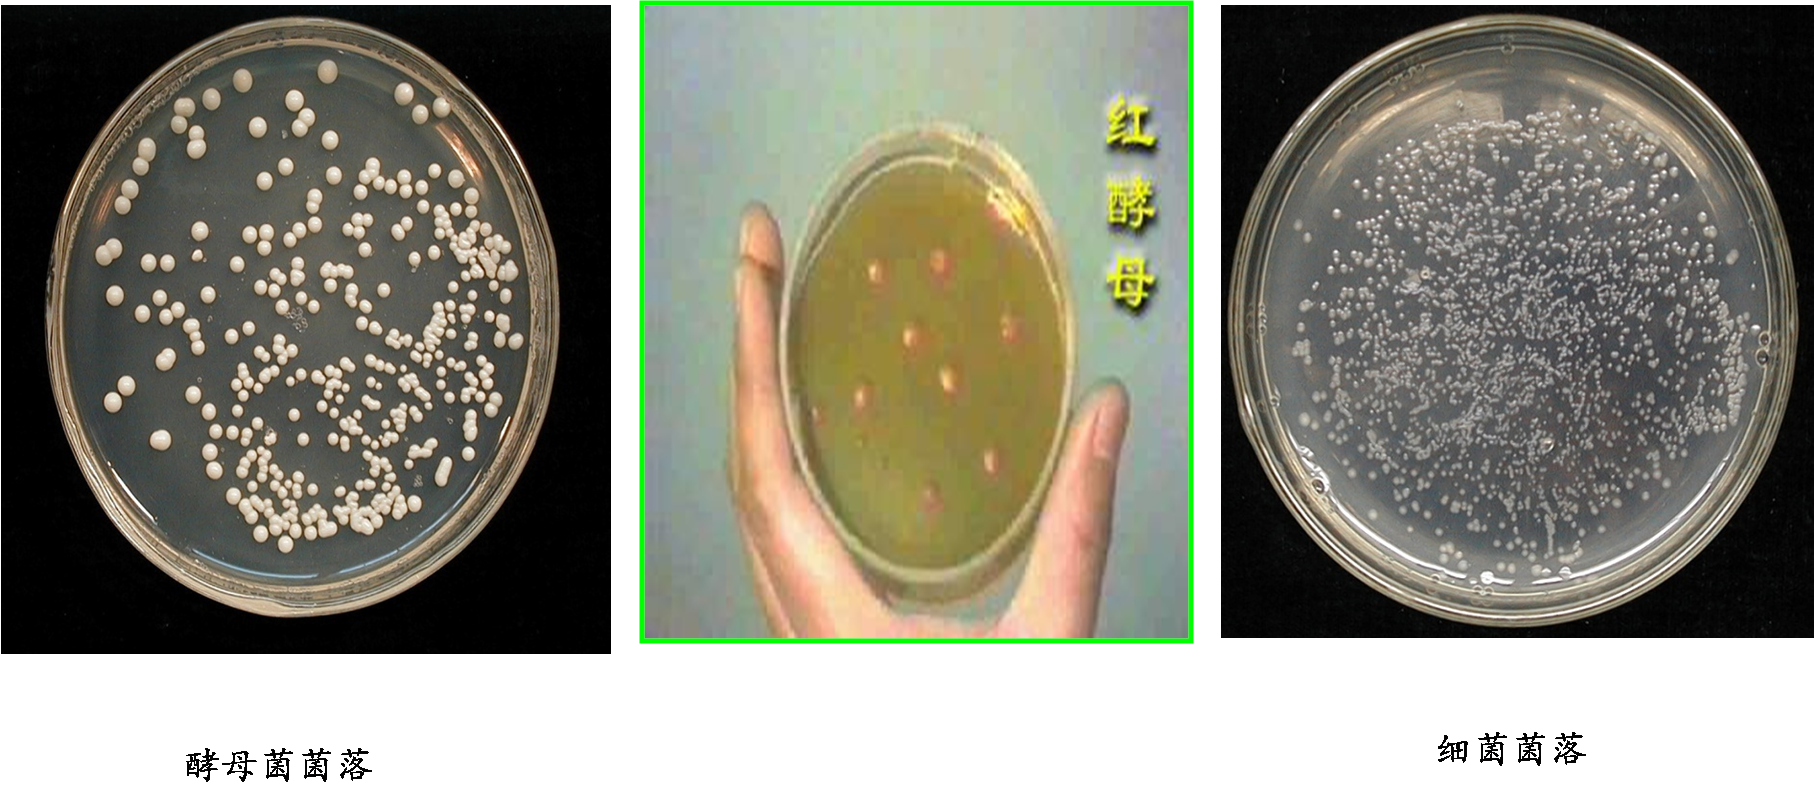

-
1 内容
-
2 练习
内容
酵母菌的个体形态、构造

酵母菌细胞形态:球形、卵圆形、椭圆形等。
酵母菌细胞结构:细胞壁、细胞质膜、细胞核、细胞质及内含物、细胞器。
◆ 细胞壁组分有:葡聚糖、甘露聚糖、蛋白质及脂类等。
◆ 细胞质膜与原核生物基本相同,但含有固醇(麦角甾醇)。
◆ 细胞核 具有核膜、核仁和染色体,核膜上有大量核孔。
◆ 细胞质 含有大量RNA、核糖体、中心体、线粒体、中心染色质、内质膜、液泡等。
◆ 内含物 在老龄菌中有因营养过剩而形成一些内含物,如:异染颗粒、肝糖,脂肪粒、蛋白质和多糖。

酵母菌的群体形态
酵母菌的繁殖方式:
◆ 无性繁殖:

◆ 有性繁殖:子囊孢子

菌落特征:
◆ 固体培养与细菌菌落类似,但一般较细菌菌落大且厚,表面湿润,粘稠,易被挑起,多为乳白色,少数呈红色。
◆ 固体培养与细菌菌落类似,但一般较细菌菌落大且厚,表面湿润,粘稠,易被挑起,多为乳白色,少数呈红色。
◆ 液体培养:在液体培养基上,不同的酵母菌生长的情况不同。好气性生长的酵母可在培养基表面上形成菌膜或菌醭,其厚度因种而异。有的酵母菌在生长过程中始终沉淀在培养基底部。有的酵母菌在培养基中均匀生长,使培养基呈浑浊状态。
酵母菌生活史

案例
1.葡萄酒酵母的分离
1)选购葡萄:选购葡萄时,可以挑选一些熟透的葡萄,哪怕是一颗颗散落的葡萄也不要紧。这些葡萄一是容易发酵,二是价位相对较低。常见的葡萄、提子、马奶子等,都是可以用来制作葡萄酒的。
2)洗葡萄:由于葡萄表皮很可能残留农药,清洗葡萄的环节就相当重要,最好能够逐颗清洗,再用自来水反复冲洗,同时剔除烂葡萄。一些爱干净的人,喜欢把葡萄去皮后酿酒,这也未尝不可,但是少了一些葡萄皮特有的营养。
3)晾干葡萄:把葡萄盛在能漏水的容器当中,等葡萄表面没有水珠就可以倒入酒坛了。
4)选择容器:酒坛子可以是陶瓷罐子,也可以是玻璃瓶,但不主张用塑料容器,因为塑料很可能会与酒精发生化学反应,并产生一些有毒物质,危害人体健康。
5)捏好葡萄放进容器:双手洗净后,直接捏葡萄,操作办法是抓起一把葡萄使劲一握,然后放入酒坛中,再把糖放在葡萄上面,葡萄和糖的比例是10∶3,即10斤葡萄放3斤糖(不喜欢吃甜的朋友,可以放2斤糖,但是不能不放糖,因为糖是葡萄发酵的重要因素)。
6)加封保存:将酒坛子密封,如果是陶瓷罐的话,可以到买黄酒的小店要点酒泥,加水后糊住封口。加封后,酒坛子需放在阴凉处保存,平时不要随意去翻动或打开盖子。
7)启封:天热时,葡萄发酵时间需要20天至一个月左右,现在这个季节做葡萄酒,发酵时间需要40天左右。启封后,捞出浮在上面的葡萄皮,就可以直接喝葡萄酒了。注意,如果喜欢酒劲足一点,只需延迟启封时间就行了。启封后,每一次舀出葡萄酒后,别忘盖好酒坛的盖子,以免酒味挥发。
2.酵母菌的怪脾气
酵母菌爱“吃糖”,但它在不同条件(有氧和无氧)下“吃糖”后生成的产物是不一样的。
酵母菌的“怪脾气”缘于它在有氧和无氧条件下均能生长,而且在不同环境条件下,它“吃糖”之后能生成不同的产物。在无氧条件下,它将98%-99%的糖发酵生成乙醇和二氧化碳,剩余1%-2%的糖被自身细胞所利用。在有氧条件下进行有氧呼吸,将糖彻底氧化成水和二氧化碳。而且在此过程中,比发酵产的能量多。因此,利用等量能源物质,酵母菌在有氧环境中午到的细胞产量,比缺氧时高得多,也就是说,在向发酵的酵母菌悬液通气的情况下,酵母菌繁殖快,发酵慢,乙醇的生成停止,这便是氧对发酵的抑制作用(巴斯德效应)。
利用酵母的“怪脾气”,当人们想要得到大量的酵母菌菌体时,就应当进行通气培养,若想利用酵母菌生产酒精、啤酒时,就要采取隔绝或排除氧气的措施。


